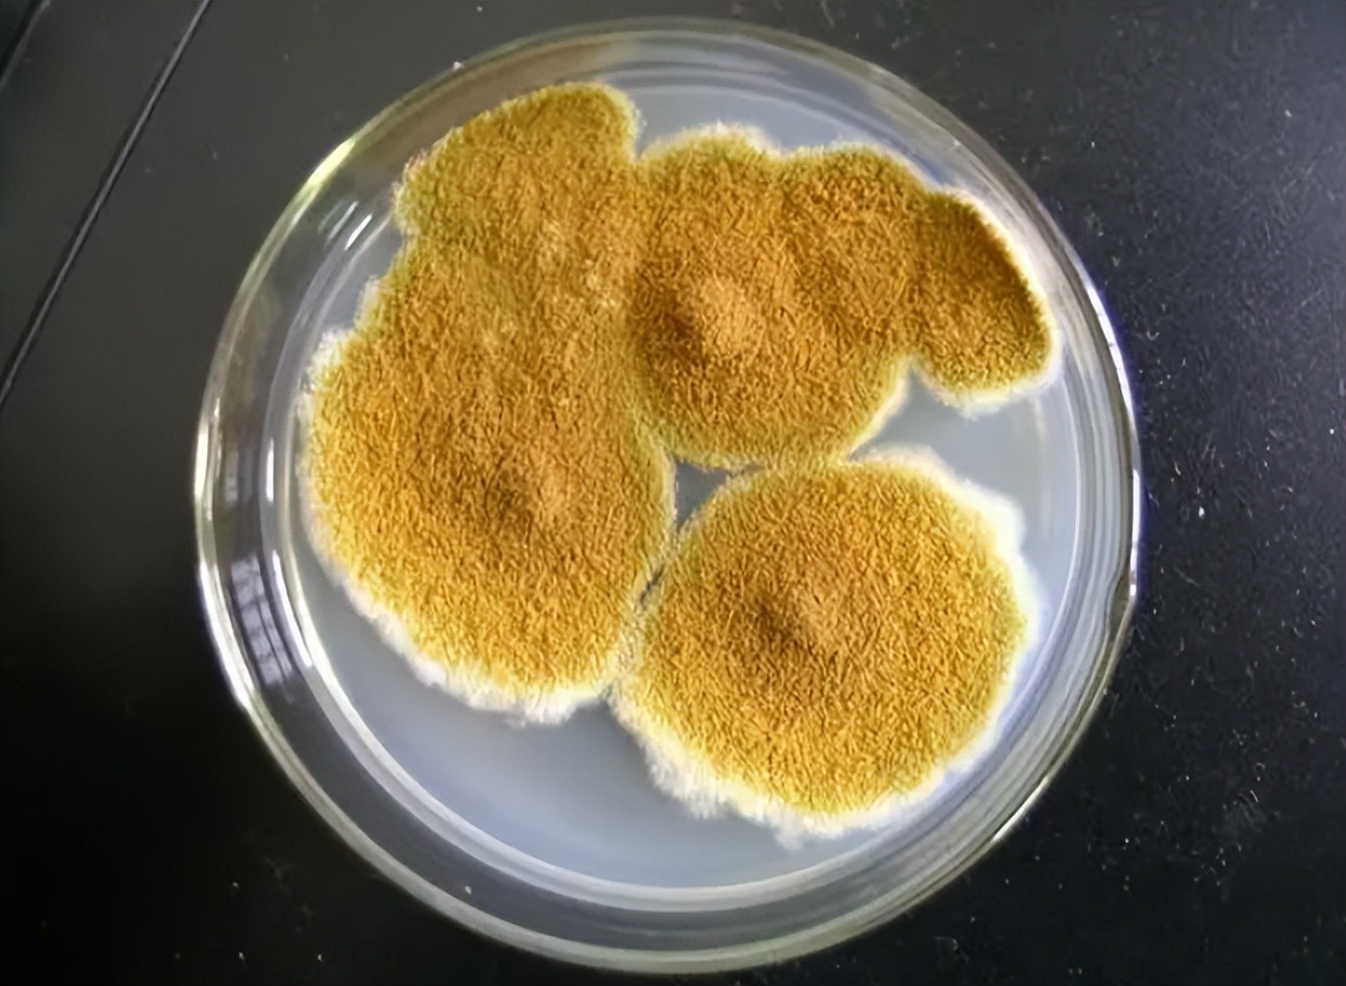
粮食中真菌的检测,粮食中真菌毒素检测的优缺点

文/小鲸鱼
编辑/小鲸鱼

粮食中真菌和细菌的生态学
微生物对植物的殖民化,几乎早在叶子暴露在空气中时就开始了,细菌通常首先定植,然后是酵母,然后是病原真菌和腐生真菌。
丝状真菌通常在植物生长的所有阶段继续发育,包括种子成熟,在收获前出现在植物上的真菌传统上被称为“田间真菌”。
通常,这些物种包括枝孢菌、链格孢菌、棘球菌、镰刀菌、镰刀菌。

枝孢子属是夏季日间空气传播孢子中最丰富的成分之一,这个属的品种在收获时广泛分布在谷物的耳朵上,交替链格孢菌是继枝孢菌之后,可能是最常见的空气传播真菌孢子。
链格孢菌可在出苗后不久在谷类作物上定居,并穿透籽粒表皮下,这使得它对杀菌剂具有耐受性,并且可以从大多数谷物中分离出来。
镰刀菌属,是谷物的重要病原体,可引起疮痂、耳腐、头枯病等各种感染,它们也可能在谷物中产生霉菌毒素,如脱氧烟腐烯醇和各种毛霉素,包括在收获前后。

猪对毛素比其他农场动物更敏感,主要症状是采食量减少和体重增加,但在猪身上也观察到免疫系统的损害。
根据谷物的贮藏条件,可能会发生典型的贮藏真菌的生长,这些真菌在收获前含量较低,主要是曲霉和青霉菌的种类。

青霉菌,一种也用于奶酪制造,是一种重要的腐败真菌在密封储存系统。
在瑞典,这种霉菌存在于酸保存的谷物中,以及在氧气排除不足的密封储存的谷物中,食用罗克福尔蒂虫感染饲料的反刍动物,表现出食欲不振、酮症、瘫痪和自然流产等症状,曲霉属是储存产品的特征殖民者,不同物种的生长需求差异很大。
因此,某些物种的优势可能表明了以前的储存条件。

另一方面,很明显,田间和贮藏植物群的概念不应该被带得太远。
该术语最初在北温带地区使用,而在更温暖、更潮湿的气候中,野外真菌和贮藏真菌之间的物种分布则不同,田间和贮藏植物区系的物种组成也可能随粮食贮藏方法的不同而有所不同。
例如,在一些潮湿的储存系统中观察到田间菌群的部分持久性。
枝孢菌,通常被认为是田间菌群,在三个被调查的农场和镰刀菌属的谷物储存后被发现,在一个农场(IV),根据之前的研究结果,Lacey和Magan指出,镰刀菌属,当aw较高、温度低时,可作为贮藏菌群发生。
然而,这种相关性不能在其中得到证实,因为aw普遍较低。

酵母在发酵谷物中的作用
真菌很少单独出现在颗粒上,但通常是细菌、酵母和丝状真菌的混合组合,酵母最出名的是它们通过发酵面包、酒精饮料对社会的贡献和其他产品。
还发表了许多关于酵母对食物和饲料变质的研究,不同属的酵母菌,如念珠菌、隐球菌、毕赤酵母、在收获时从谷物中分离出红霉和孢子菌。
然而,它们的存在,因为丝状真菌通常被认为是谷物采前和采后变质的主要因素,采后变质,是由于干燥不足或随后由于储存设备不良导致的水分增加引起的。
然而,酵母与采前和采后退化相关的酵母的重要性,还需要进一步的研究。

很明显,酵母在发酵谷物的生产和腐败中起着重要的作用,虽然LAB主要负责青贮发酵,但酵母可能与LAB竞争可发酵的生长底物,空气进入激活酵母的生长,可能导致快速恶化,因为一些酵母可以代谢乳酸和醋酸,导致pH增加,并促进腐败细菌和霉菌的生长。
另一方面,酵母可以抑制霉菌生长,作为SCP使用,并可能对胃肠道有积极作用。
收获时,谷物的aw一般为0.86~0.97,含水量为15-25%,在收获前的田间,谷物通常含有大约6.5 log单位g-1新鲜物质的细菌。

然而,这些数字在不同的微生物群和生产地点之间,可能有很大的差异,一般来说,粮食储存期间的控制措施并不关注细菌,因为它们不被认为是问题微生物。
支持大多数革兰氏阴性菌和革兰氏阳性菌活跃生长的最小aw分别为0.97和0.90,细菌状态通常通过测定一般底物上需氧细菌的总数来评估,作为饲料卫生状态的指示。
植物表面的主要菌群是革兰氏阴性菌,欧文菌、假单胞菌和黄单胞菌,革兰氏阳性菌,如乳酸菌和亮梭菌。

这可能在发酵饲料的生产中非常重要,论文证实了谷物中存在乳酸菌和亮念珠菌,但在收获时谷物中也存在芽孢杆菌、肠球菌、乳球菌、球片球菌和魏氏菌。
肠杆菌科的存在表明了饲料的一般卫生状况,较高的cfu值意味着需要对潜在的有害生物体进行进一步的研究,然而,这些细菌通常不被评估,因为谷物的aw不支持它们的生长,我们发现,它们在收获时在谷物上的存在相当大,远远超过瑞典青贮饲料的指导值(表4见下)。
这表明, 在使用不同技术系统储存的谷物饲料卫生评价中,包括这一微生物群的重要性。
微生物饲料卫生
通过评价其一般微生物状态来评价饲料的卫生质量,饲料或饲料成分的微生物质量可能会对动物的生产和生产性能产生负面影响。
不同的饲料可能构成各种风险, 这取决于管理、组成、生产地点、天气条件等 ,在瑞典,不同饲料中可接受的微生物最高水平仅以建议的形式表示,即不作为立法的最高水平。
然而,这些水平确实提供了所需的卫生状况的指示,超过该值并不一定意味着危险饲料,但表明有害饲料的风险增加,需要进行个案评估。

表4
没有关于所有饲料的各种微生物的允许水平的数据,因此,对某些饲料卫生的评价是基于估计的,饲料卫生主要受含水量的影响,因为高aw可能允许在储存过程中的细菌和真菌生长,从而降低饲料的质量。
方法与培养
确定微生物的多样性一直是一个挑战,传统的方法依赖于基因培养的技术,可能只能恢复环境中的一小部分微生物。
目前对土壤和水的估计表明,不可培养微生物的数量约为99%,尽管一些调查报告已恢复了微生物总数的4%。

此外,微生物培养的过程虽然由于新方法的发展而有所改进,但耗时、劳动密集,对微生物空间分布的了解有限,然而,这是分离不同生物体菌株的唯一方法,这些菌株可以进一步用作发酵剂培养物(II、IV、V和VI)。
根据北欧食品分析委员会的建议,采用了在饲料卫生评估中使用的基于文化的技术。
根据一般的微生物学原理,采用稀释系列法制备饲料样品,每克饲料的活微生物数菌落在选定的培养皿上计数,对de Man、Rogosa和夏琼脂进行LAB计数,该方法代表了一种适用于所有类型的食物和饲料的一般方法。

然而,LAB物种的最佳生长需求可能有很大差异,因此,这种方法可能并不总是平等地支持所有LAB的生长,饲料中LAB的数量提供了发酵过程的指示。
色氨酸葡萄糖提取物琼脂(TGEA)是一种计数需氧细菌的一般底物,提供了饲料中细菌负荷的一般图片。
好氧培养皿的数量是通过在培养皿中加入熔融琼脂,该方法被认为不适用于确定发酵饲料的卫生条件,因为基于16S rRNA基因的鉴定显示,TGEA上的大多数菌落是LAB,这在饲料中是理想的。

肠杆菌科是一种兼性厌氧的革兰氏阴性杆状菌科,计数是在紫红胆汁葡萄糖琼脂中进行的,肠杆菌科计数可作为卫生质量的一般指标。
耐热大肠菌群,如大肠杆菌,也在VRBG上通过在升高的温度下孵育,饲料中大肠杆菌的存在强烈表明了一些粪便污染的历史。
梭状芽孢杆菌在强化梭状芽孢杆菌培养基上被列举,这估计了厌氧孢子形成细菌的总数,因为样品在电镀前在80°C下保持13分钟。

酵母和霉菌的定量测定在二氯甘油琼脂(DG18)上用于降低aw(< 0.95),培养后分别计算酵母和酵母,麦芽提取物琼脂(MEA)也可以用于分离霉菌和酵母,如果不需要降低水活性。
枚举方法提供的是数字,而不是关于群落系统发育或多样性的信息,然而,由于细胞在固体培养基上被计数为单独的菌落,单个菌落很容易被分离出来并进行进一步的分析。

实时PCR-另一种量化物种的方法
实时PCR可用于定量食品和饲料样品中的不同物种,已被证明,在非均匀底物的混合物种发酵中,它可以快速和选择性地量化真菌种类,实时PCR的显著特点是扩增过程是使用荧光技术进行实时监测。
通过与已知标准的比较,得到的扩增曲线可以高精度地定量模板分子的初始量,由于实时PCR提供了整个扩增谱,很容易检测到其扩增效率有偏差的个体反应。
然而,该方法可能不能直接用于饲料样品,因为需要引物设计来检测感兴趣的种类,由于饲料样品中的微生物组成或多或少未知,该方法不能直接应用,另一方面,该方法在量化方面最为有用。

分子法的物种鉴定
通过对rRNA基因的PCR扩增,对分离的LAB和酵母菌株进行了物种水平的鉴定,这些序列通常用于分类分化。
在进行序列鉴定之前,对II、II、V、V、VI分离的菌株按基因型进行鉴定,使用GelCompar II V4.5软件对重复dna元素PCR指纹分析产生的条带模式进行分析,构建了一个树状图,并从每个聚类中选择一个有代表性的菌株进行鉴定。
对代表性菌株的rRNA基因进行测序,以确定谷物中存在的种类,对选定酵母进行序列分析,使用引物NL1和NL4扩增25S rRNA基因的D1/D2区域。

微生物群落的变性梯度凝胶电泳(DGGE)分析产生了一个复杂的轮廓,它可能对空间和时间的采样变化相当敏感,该方法根据G-C含量的差异分离pcr扩增的rDNA,代表群落结构的扩增子在带有dna变性化合物梯度的聚丙烯酰胺凝胶上运行。
当DNA通过梯度时,细胞链被依次分离,在PCR过程中使用的引物中,GC钳被合并到扩增的DNA中,GC钳夹可以防止DNA的完全变性。
然而,DNA的变性增加降低了它的流动性,当它几乎完全变性时,它最终停止。

作者观点
因此,G-C含量的差异导致扩增子迁移到凝胶中的不同位置。
精确校准的DGGE足够敏感,可以显示扩增子中的单个碱基对差异,对于分类学鉴定,条带可以被测序,DGGE在这里处于劣势,因为DN*片A**段的大小通常低于500 bp,这限制了可用于鉴定的序列的数量。
与所有基于pcr的rDNA指纹分析方法一样,将群落中的单个条带与单个微生物物种进行关联起来缺乏精确性,因为多个扩增子可能共同迁移到凝胶中的同一位置,所以,实时PCR和分子法各有优劣。

参考文献:
- 琼森,N.和佩特森,H.(2000)。提高了空气基础分析仪的应用价值。
- 基斯A.K.,P. A.和乔恩布洛德,A.W.(2006)。蛋白质、植酸盐和微生物植酸酶之间的相互作用。
- 利奇菲尔德,J.H.。(1983).单细胞蛋白。
- 莱伯格,西蒙森。(2005).磷肥水平和食物浸泡对生育肥育猪磷利用率和生产性能的影响。